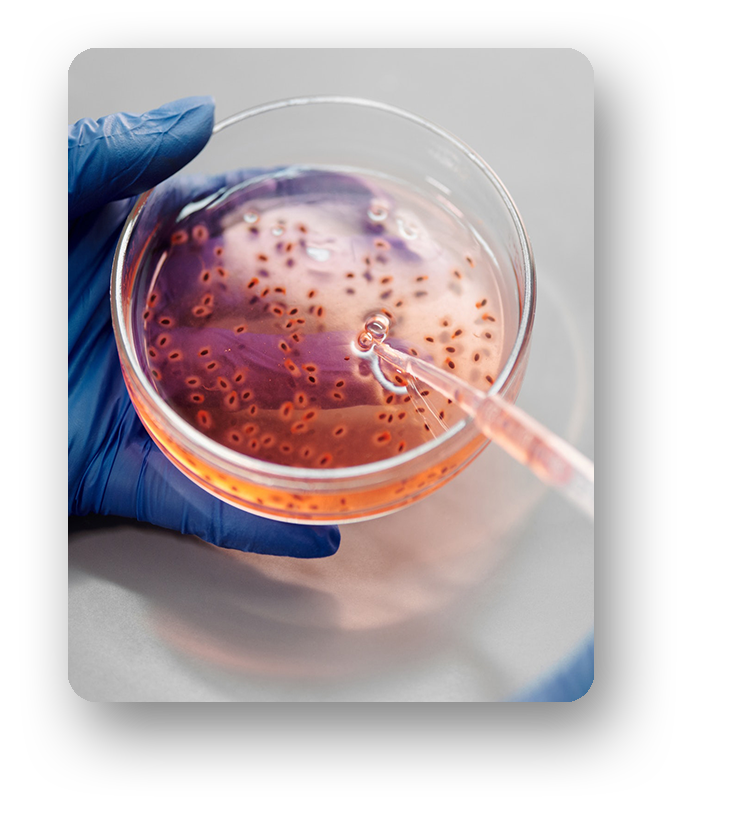

Lotus Bioscience Nepal Pvt. Ltd., based in Nepal is a global In-Vitro Diagnostic Distribution Firm bringing in specially selected immunoassay products for the Nepalese Customers.

Our trained & dedicated team of Sales & Support professionals are trained to assist you 24x7 / 365.

The company specializes in providing range of support and services to its immunoassay customers.

We understand the importance of speed in today's fast pace changing healthcare scenario.
Pioneering in the field on Immunoassay it offers its customers the best technologies available in the world market.
Customer Support
Unlimited Care
Quick Response Time
Having any queries ? Feel free to contact us.